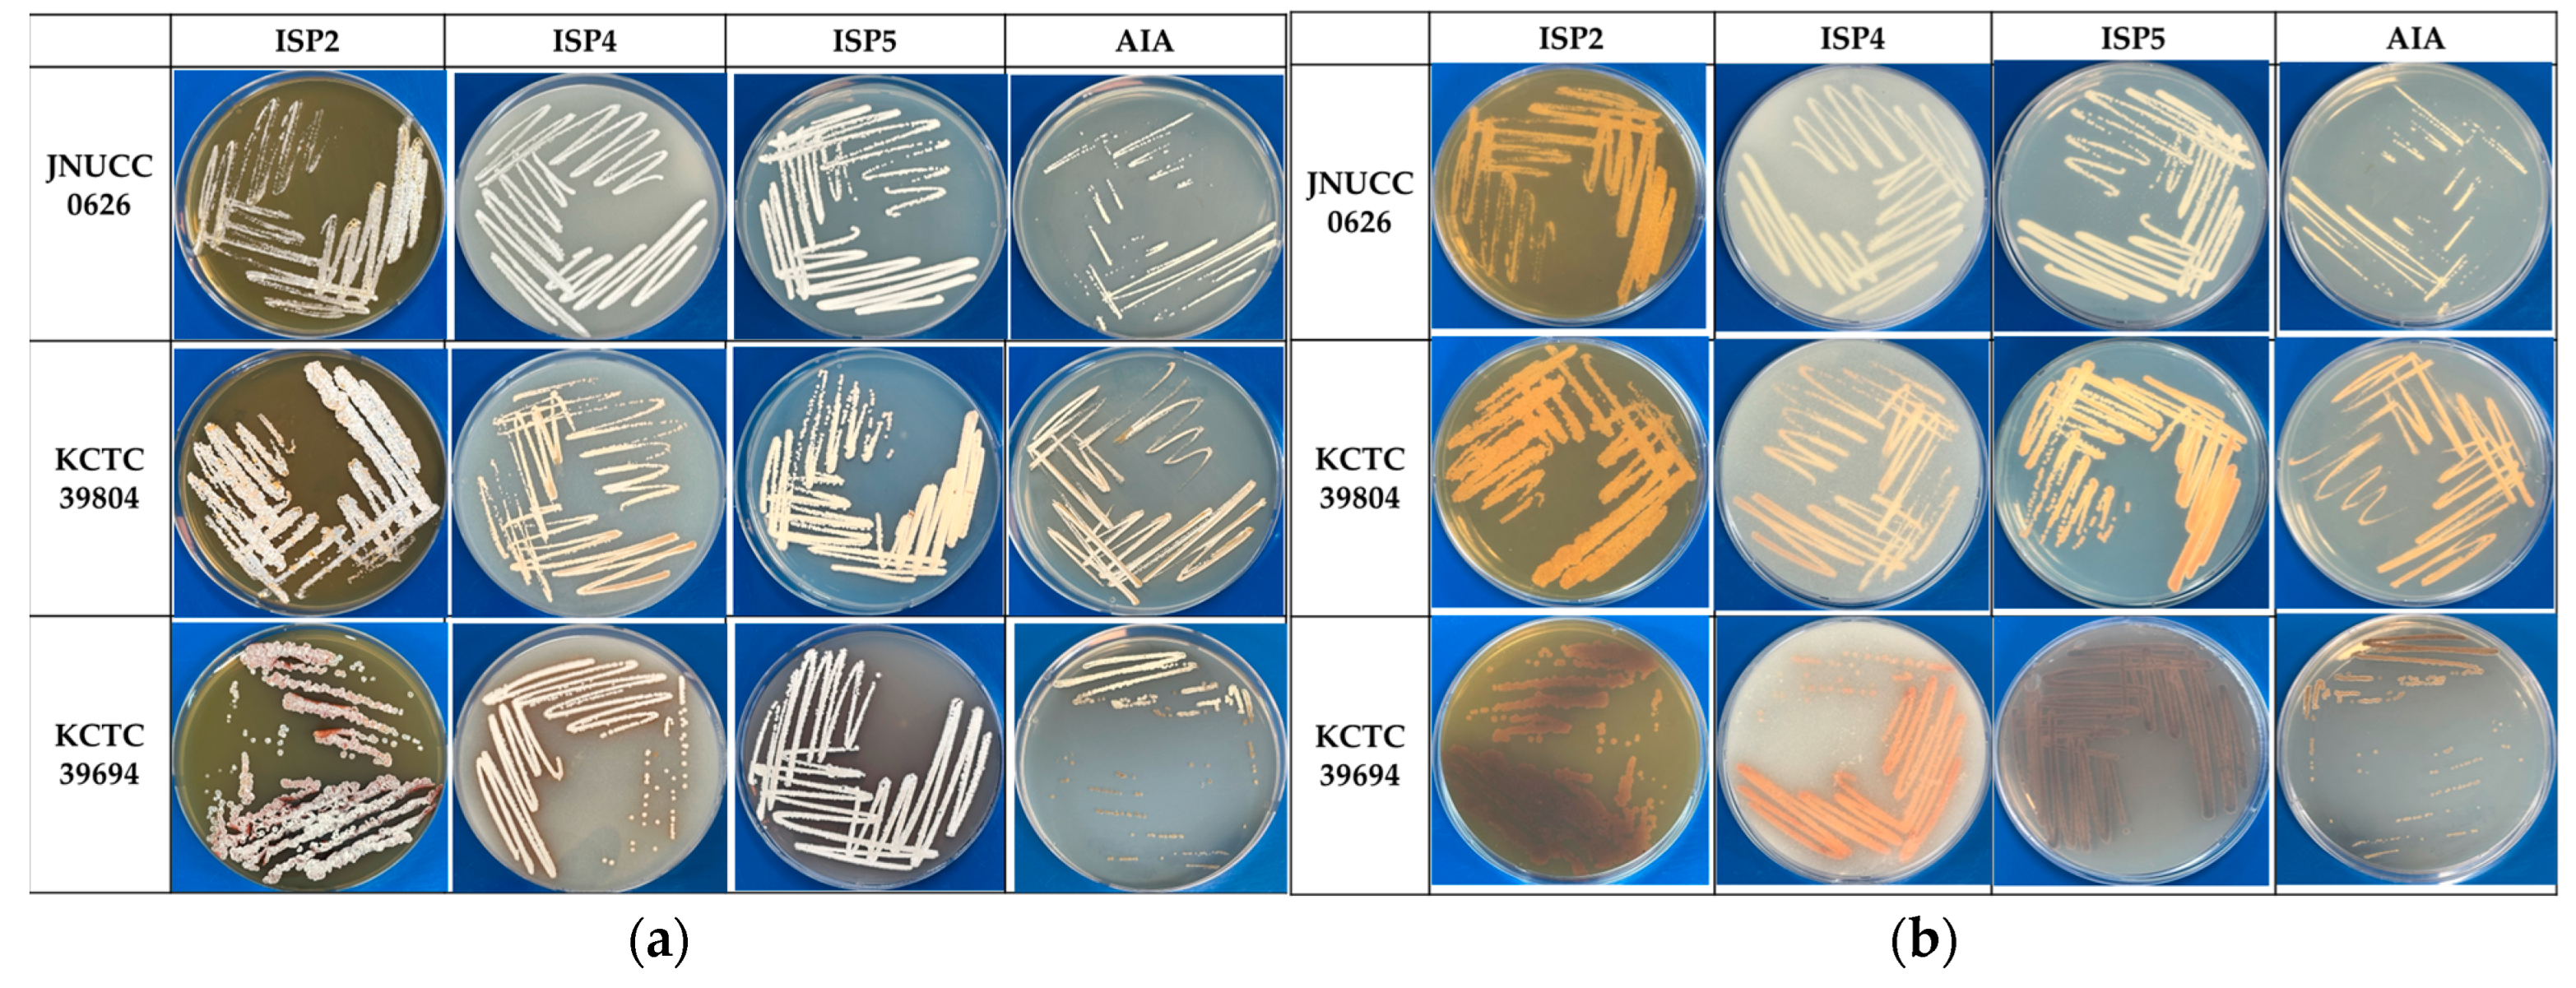

Taxonomic Identification, Complete Genome Sequencing, and In Silico Genome Mining of the Actinobacterium Lentzea sp. JNUCC 0626 Isolated from Jeju Gotjawal
Abstract
1. Introduction
2. Materials and Methods
2.1. Media and Chemicals
2.2. Taxonomic Characterization of Lentzea sp. JNUCC 0626
2.3. Fermentation and Sample Preparation for Anti-Inflammatory Assays
2.4. Cell Culture, Cell Viability, and Anti-Inflammatory Efficacy
2.5. Genome De Novo Sequencing, Assembly, and Annotation
2.6. Comparative Genomic Studies and Genome Mining of the Lentzea sp. JNUCC 0626
2.7. Statistical Analysis
3. Results and Discussion
3.1. Taxonomic Characterization of Lentzea sp. JNUCC 0626
3.2. Sequencing, Assembly, and Genomic Characteristics
3.3. Characterization of Lentzea sp. JNUCC 0626 as a Novel Strain via dDDH Analysis
3.4. Characterization of Lentzea sp. JNUCC 0626 as a Novel Strain via ANI Analysis
3.5. Analysis of Plasmid Presence and Antibiotic Resistance Genes
3.6. In Silico Prediction of Secondary Metabolites and Biosynthetic Gene Cluster Analysis of Lentzea sp. JNUCC 0626
3.6.1. Terpene-Related Gene Clusters
BGC Region 1 Derived from Lentzea sp. JNUCC 0626
BGC Region 3 Derived from Lentzea sp. JNUCC 0626
BGC Region 6 Derived from Lentzea sp. JNUCC 0626
BGC Region 23 Derived from Lentzea sp. JNUCC 0626
BGC Region 26 Derived from Lentzea sp. JNUCC 0626
3.6.2. Thiopeptide and LAP Gene Clusters
BGC Region 2 Derived from Lentzea sp. JNUCC 0626
BGC Region 31 Derived from Lentzea sp. JNUCC 0626
3.6.3. Lanthipeptide and RiPP Gene Clusters
BGC Region 5 Derived from Lentzea sp. JNUCC 0626
BGC Region 13 Derived from Lentzea sp. JNUCC 0626
BGC Region 19 Derived from Lentzea sp. JNUCC 0626
BGC Region 21 Derived from Lentzea sp. JNUCC 0626
BGC Region 22 Derived from Lentzea sp. JNUCC 0626
BGC Region 25 Derived from Lentzea sp. JNUCC 0626
3.6.4. Indole-Related Gene Clusters
BGC Region 7 Derived from Lentzea sp. JNUCC 0626
BGC Region 20 Derived from Lentzea sp. JNUCC 0626
3.6.5. NRPS and PKS Gene Clusters
BGC Region 8 Derived from Lentzea sp. JNUCC 0626
BGC Region 9 Derived from Lentzea sp. JNUCC 0626
BGC Region 10 Derived from Lentzea sp. JNUCC 0626
BGC Region 11 Derived from Lentzea sp. JNUCC 0626
BGC Region 12 Derived from Lentzea sp. JNUCC 0626
BGC Region 15 Derived from Lentzea sp. JNUCC 0626
BGC Region 16 Derived from Lentzea sp. JNUCC 0626
BGC Region 17 Derived from Lentzea sp. JNUCC 0626
BGC Region 24 Derived from Lentzea sp. JNUCC 0626
BGC Region 33 Derived from Lentzea sp. JNUCC 0626
BGC Region 34 Derived from Lentzea sp. JNUCC 0626
3.6.6. Other Gene Clusters
BGC Region 4 Derived from Lentzea sp. JNUCC 0626
BGC Region 14 Derived from Lentzea sp. JNUCC 0626
BGC Region 18 Derived from Lentzea sp. JNUCC 0626
BGC Region 27 Derived from Lentzea sp. JNUCC 0626
BGC Region 28 Derived from Lentzea sp. JNUCC 0626
BGC Region 29 Derived from Lentzea sp. JNUCC 0626
BGC Region 30 Derived from Lentzea sp. JNUCC 0626
BGC Region 32 Derived from Lentzea sp. JNUCC 0626
3.7. Anti-Inflammatory Capacity of Lentzea sp. JNUCC 0626
4. Conclusions
Supplementary Materials
Author Contributions
Funding
Institutional Review Board Statement
Informed Consent Statement
Data Availability Statement
Conflicts of Interest
References
- Jagannathan, S.V.; Manemann, E.M.; Rowe, S.E.; Callender, M.C.; Soto, W. Marine Actinomycetes, New Sources of Biotechnological Products. Mar. Drugs. 2021, 19, 365. [Google Scholar] [CrossRef] [PubMed]
- Katz, L.; Baltz, R.H. Natural product discovery: Past, present, and future. J. Ind. Microbiol. Biotechnol. 2016, 43, 155–176. [Google Scholar] [CrossRef] [PubMed]
- Li, L. Accessing hidden microbial biosynthetic potential from underexplored sources for novel drug discovery. Biotechnol. Adv. 2023, 66, 108176. [Google Scholar] [CrossRef]
- Selim, M.S.M.; Abdelhamid, S.A.; Mohamed, S.S. Secondary metabolites and biodiversity of actinomycetes. J. Genet. Eng. Biotechnol. 2021, 19, 72. [Google Scholar] [CrossRef] [PubMed]
- Hemmerling, F.; Piel, J. Strategies to access biosynthetic novelty in bacterial genomes for drug discovery. Nat. Rev. Drug Discov. 2022, 21, 359–378. [Google Scholar] [CrossRef] [PubMed]
- van Bergeijk, D.A.; Terlouw, B.R.; Medema, M.H.; van Wezel, G.P. Ecology and genomics of Actinobacteria: New concepts for natural product discovery. Nat. Rev. Microbiol. 2020, 18, 546–558. [Google Scholar] [CrossRef]
- Girão, M.; Ribeiro, I.; Carvalho, M.d.F. Actinobacteria from Marine Environments: A Unique Source of Natural Products. In Natural Products from Actinomycetes: Diversity, Ecology and Drug Discovery; Springer: Berlin/Heidelberg, Germany, 2022; pp. 1–45. [Google Scholar]
- González-Salazar, L.A.; Quezada, M.; Rodríguez-Orduña, L.; Ramos-Aboites, H.; Capon, R.J.; Souza-Saldívar, V.; Barona-Gomez, F.; Licona-Cassani, C. Biosynthetic novelty index reveals the metabolic potential of rare actinobacteria isolated from highly oligotrophic sediments. Microb. Genom. 2023, 9, mgen000921. [Google Scholar] [CrossRef]
- van Santen, J.A.; Poynton, E.F.; Iskakova, D.; McMann, E.; Alsup, T.A.; Clark, T.N.; Fergusson, C.H.; Fewer, D.P.; Hughes, A.H.; McCadden, C.A.; et al. The Natural Products Atlas 2.0: A database of microbially-derived natural products. Nucleic Acids Res. 2022, 50, D1317–D1323. [Google Scholar] [CrossRef]
- Parra, J.; Beaton, A.; Seipke, R.F.; Wilkinson, B.; Hutchings, M.I.; Duncan, K.R. Antibiotics from rare actinomycetes, beyond the genus Streptomyces. Curr. Opin. Microbiol. 2023, 76, 102385. [Google Scholar] [CrossRef] [PubMed]
- Beck, M.L.; Song, S.; Shuster, I.E.; Miharia, A.; Walker, A.S. Diversity and taxonomic distribution of bacterial biosynthetic gene clusters predicted to produce compounds with therapeutically relevant bioactivities. J. Ind. Microbiol. Biotechnol. 2023, 50, kuad024. [Google Scholar] [CrossRef]
- Maiti, P.K.; Mandal, S. Comprehensive genome analysis of Lentzea reveals repertoire of polymer-degrading enzymes and bioactive compounds with clinical relevance. Sci. Rep. 2022, 12, 8409. [Google Scholar] [CrossRef] [PubMed]
- Albarano, L.; Esposito, R.; Ruocco, N.; Costantini, M. Genome Mining as New Challenge in Natural Products Discovery. Mar. Drugs. 2020, 18, 199. [Google Scholar] [CrossRef]
- Aborode, A.T.; Awuah, W.A.; Mikhailova, T.; Abdul-Rahman, T.; Pavlock, S.; Kundu, M.; Yarlagadda, R.; Pustake, M.; Correia, I.F.D.S.; Mehmood, Q.; et al. OMICs Technologies for Natural Compounds-based Drug Development. Curr. Top. Med. Chem. 2022, 22, 1751–1765. [Google Scholar] [CrossRef]
- Zhang, H.W.; Lv, C.; Zhang, L.J.; Guo, X.; Shen, Y.W.; Nagle, D.G.; Zhou, Y.D.; Liu, S.H.; Zhang, W.D.; Luan, X. Application of omics- and multi-omics-based techniques for natural product target discovery. Biomed. Pharmacother. 2021, 141, 111833. [Google Scholar] [CrossRef]
- Espinosa, E.; Bautista, R.; Larrosa, R.; Plata, O. Advancements in long-read genome sequencing technologies and algorithms. Genomics 2024, 116, 110842. [Google Scholar] [CrossRef] [PubMed]
- Rajwani, R.; Ohlemacher, S.I.; Zhao, G.; Liu, H.B.; Bewley, C.A. Genome-Guided Discovery of Natural Products through Multiplexed Low-Coverage Whole-Genome Sequencing of Soil Actinomycetes on Oxford Nanopore Flongle. mSystems 2021, 6, e0102021. [Google Scholar] [CrossRef] [PubMed]
- Biermann, F.; Wenski, S.L.; Helfrich, E.J.N. Navigating and expanding the roadmap of natural product genome mining tools. Beilstein J. Org. Chem. 2022, 18, 1656–1671. [Google Scholar] [CrossRef] [PubMed]
- Malit, J.J.L.; Leung, H.Y.C.; Qian, P.Y. Targeted Large-Scale Genome Mining and Candidate Prioritization for Natural Product Discovery. Mar. Drugs. 2022, 20, 398. [Google Scholar] [CrossRef] [PubMed]
- Medema, M.H.; de Rond, T.; Moore, B.S. Mining genomes to illuminate the specialized chemistry of life. Nat. Rev. Genet. 2021, 22, 553–571. [Google Scholar] [CrossRef]
- Hong, C.Y.; Yoon, R.; Hwang, J.D.; Jwa, M.S. Exploring Community Symbiotic Tourism Programs for the Utilization and Conservation of Ecology in Lava Stony Forest (Gotjawal) of Jeju Island, Korea. Sustainability 2020, 12, 8371. [Google Scholar] [CrossRef]
- Kim, J.S.; Kim, D.S.; Lee, K.C.; Lee, J.S.; King, G.M.; Kang, S. Microbial community structure and functional potential of lava-formed Gotjawal soils in Jeju, Korea. PLoS ONE 2018, 13, e0204761. [Google Scholar] [CrossRef] [PubMed]
- Hernández, M.; Calabi, M.; Conrad, R.; Dumont, M.G. Analysis of the microbial communities in soils of different ages following volcanic eruptions. Pedosphere 2020, 30, 126–134. [Google Scholar] [CrossRef]
- Kim, K.K.; Lee, K.C.; Eom, M.K.; Kim, J.S.; Kim, D.S.; Ko, S.H.; Lee, J.S. Variibacter gotjawalensis gen. nov., sp. nov., isolated from soil of a lava forest. Antonie Van Leeuwenhoek 2014, 105, 915–924. [Google Scholar] [CrossRef]
- Kim, M.; Cha, I.T.; Lee, K.E.; Park, S.J. Chryseobacterium gotjawalense sp. nov. Isolated from Soil in the Volcanic Forest Gotjawal, Jeju Island. Curr. Microbiol. 2024, 81, 187. [Google Scholar] [CrossRef] [PubMed]
- Um, S.; Lee, J.; Kim, S.H. Lobophorin Producing Endophytic Streptomyces olivaceus JB1 Associated With Maesa japonica (Thunb.) Moritzi & Zoll. Front. Microbiol. 2022, 13, 881253. [Google Scholar] [CrossRef]
- Hyun, K.A.; Xu, Y.; Boo, K.H.; Hyun, C.G. 1-Acetyl-β-Carboline from a Jeju Gotjawal Strain Lentzea sp. JNUCC 0626 and Its Melanogenic Stimulating Activity in B16F10 Melanoma Cells. Molecules 2024, 29, 4586. [Google Scholar] [CrossRef]
- Li, X.; Zhang, L.; Huang, F.; Zhao, J.; Wang, H.; Jiao, Y.; Qian, L.; Wang, X.; Xiang, W. Microbacterium helvum sp. nov., a novel actinobacterium isolated from cow dung. Arch. Microbiol. 2021, 203, 3287–3294. [Google Scholar] [CrossRef]
- Hu, H.Y.; Lim, B.R.; Goto, N.; Bhupathiraju, V.K.; Fujie, K. Characterization of microbial community in an activated sludge process treating domestic wastewater using quinone profiles. Water Sci. Technol. 2001, 43, 99–106. [Google Scholar] [CrossRef] [PubMed]
- Minnikin, D.E.; Minnikin, S.M.; Parlett, J.H.; Goodfellow, M.; Magnusson, M. Mycolic acid patterns of some species of Mycobacterium. Arch. Microbiol. 1984, 139, 225–231. [Google Scholar] [CrossRef] [PubMed]
- Koren, S.; Walenz, B.P.; Berlin, K.; Miller, J.R.; Bergman, N.H.; Phillippy, A.M. Canu: Scalable and accurate long-read assembly via adaptive k-mer weighting and repeat separation. Genome Res. 2017, 27, 722–736. [Google Scholar] [CrossRef] [PubMed]
- Hunt, M.; Silva, N.D.; Otto, T.D.; Parkhill, J.; Keane, J.A.; Harris, S.R. Circlator: Automated circularization of genome assemblies using long sequencing reads. Genome Biol. 2015, 16, 294. [Google Scholar] [CrossRef] [PubMed]
- Tatusova, T.; DiCuccio, M.; Badretdin, A.; Chetvernin, V.; Nawrocki, E.P.; Zaslavsky, L.; Lomsadze, A.; Pruitt, K.D.; Borodovsky, M.; Ostell, J. NCBI prokaryotic genome annotation pipeline. Nucleic Acids Res. 2016, 44, 6614–6624. [Google Scholar] [CrossRef]
- Meier-Kolthoff, J.P.; Carbasse, J.S.; Peinado-Olarte, R.L.; Göker, M. TYGS and LPSN: A database tandem for fast and re-liable genome-based classification and nomenclature of prokaryotes. Nucleic Acids Res. 2022, 50, D801–D807. [Google Scholar] [CrossRef]
- Chalita, M.; Kim, Y.O.; Park, S.; Oh, H.S.; Cho, J.H.; Moon, J.; Baek, N.; Moon, C.; Lee, K.; Yang, J.; et al. EzBioCloud: A genome-driven database and platform for microbiome identification and discovery. Int. J. Syst. Evol. Microbiol. 2024, 74, 006421. [Google Scholar] [CrossRef] [PubMed]
- Blin, K.; Shaw, S.; Augustijn, H.E.; Reitz, Z.L.; Biermann, F.; Alanjary, M.; Fetter, A.; Terlouw, B.R.; Metcalf, W.W.; Helfrich, E.J.N.; et al. antiSMASH 7.0: New and improved predictions for detection, regulation, chemical structures and visualisation. Nucleic Acids Res. 2023, 51, W46–W50. [Google Scholar] [CrossRef]
- van Heel, A.J.; de Jong, A.; Song, C.; Viel, J.H.; Kok, J.; Kuipers, O.P. BAGEL4: A user-friendly web server to thoroughly mine RiPPs and bacteriocins. Nucleic Acids Res. 2018, 46, W278–W281. [Google Scholar] [CrossRef] [PubMed]
- Skinnider, M.A.; Johnston, C.W.; Gunabalasingam, M.; Merwin, N.J.; Kieliszek, A.M.; MacLellan, R.J.; Li, H.; Ranieri, M.R.M.; Webster, A.L.H.; Cao, M.P.T.; et al. Comprehensive prediction of secondary metabolite structure and biological activity from microbial genome sequences. Nat. Commun. 2020, 11, 6058. [Google Scholar] [CrossRef]
- Deng, A.; Fu, L.; Mo, P.; Zheng, Y.; Tang, T.; Gao, J. New insights into the relationship between the average nucleotide identity and the digital DNA-DNA hybridization values in the genus Amycolatopsis and Amycolatopsis cynarae sp. nov., a novel actinobacterium from the rhizosphere soil of Cynara scolymus, and proposal of Amycolatopsis niigatensis as a synonym of Amycolatopsis echigonensis based on comparative genomic analysis. Front. Microbiol. 2024, 15, 1359021. [Google Scholar] [CrossRef]
- Alvarez-Martinez, C.E.; Christie, P.J. Biological diversity of prokaryotic type IV secretion systems. Microbiol. Mol. Biol. Rev. 2009, 73, 775–808. [Google Scholar] [CrossRef] [PubMed]
- Kohler, V.; Keller, W.; Grohmann, E. Regulation of Gram-Positive Conjugation. Front. Microbiol. 2019, 10, 1134. [Google Scholar] [CrossRef]
- McLean, T.C.; Le, T.B. CTP switches in ParABS-mediated bacterial chromosome segregation and beyond. Curr. Opin. Microbiol. 2023, 73, 102289. [Google Scholar] [CrossRef] [PubMed]
- Feng, Y.; Qaseem, A.; Moumbock, A.F.A.; Pan, S.; Kirchner, P.A.; Simoben, C.V.; Malange, Y.I.; Babiaka, S.B.; Gao, M.; Günther, S. StreptomeDB 4.0: A comprehensive database of streptomycetes natural products enriched with protein interactions and interactive spectral visualization. Nucleic. Acids Res. 2024, 53, gkae1030. [Google Scholar] [CrossRef]
- Hyun, K.A.; Kim, S.Y.; Boo, K.H.; Chi, W.J.; Hyun, C.G. Complete Genome Sequence of the Butirosin-Producing Bacillus vitellinus NBRC 13296 and Its Reclassification to Paenibacillus chitinolyticus. Microbiol. Res. 2024, 15, 1747. [Google Scholar] [CrossRef]
- Hyun, K.A.; Liang, X.; Xu, Y.; Kim, S.Y.; Boo, K.H.; Park, J.S.; Chi, W.J.; Hyun, C.G. Analysis of the Setomimycin Biosynthetic Gene Cluster from Streptomyces nojiriensis JCM3382 and Evaluation of Its α-Glucosidase Inhibitory Activity Using Molecular Docking and Molecular Dynamics Simulations. Int. J. Mol. Sci. 2024, 25, 10758. [Google Scholar] [CrossRef] [PubMed]
- Kschowak, M.J.; Maier, F.; Wortmann, H.; Buchhaupt, M. Analyzing and Engineering the Product Selectivity of a 2-Methylenebornane Synthase. ACS Synth. Biol. 2020, 9, 981–986. [Google Scholar] [CrossRef]
- Andreas, M.P.; Giessen, T.W. The biosynthesis of the odorant 2-methylisoborneol is compartmentalized inside a protein shell. bioRxiv 2024. [Google Scholar] [CrossRef] [PubMed]
- Hayashi, S.; Ozaki, T.; Asamizu, S.; Ikeda, H.; Ōmura, S.; Oku, N.; Igarashi, Y.; Tomoda, H.; Onaka, H. Genome mining reveals a minimum gene set for the biosynthesis of 32-membered macrocyclic thiopeptides lactazoles. Chem. Biol. 2014, 21, 679–688. [Google Scholar] [CrossRef]
- Yang, X.; Wu, L.; Ran, Y.; Xu, A.; Zhang, B.; Yang, X.; Zhang, R.; Rao, Z.; Li, J. Crystal structure of l-glutamate N-acetyltransferase ArgA from Mycobacterium tuberculosis. Biochim. Biophys. Acta Proteins Proteom. 2017, 1865, 1800–1807. [Google Scholar] [CrossRef]
- Ayikpoe, R.S.; Zhu, L.; Chen, J.Y.; Ting, C.P.; van der Donk, W.A. Macrocyclization and Backbone Rearrangement During RiPP Biosynthesis by a SAM-Dependent Domain-of-Unknown-Function 692. ACS Cent. Sci. 2023, 9, 1008–1018. [Google Scholar] [CrossRef]
- Kim, S.; Lee, K.; Park, S.H.; Kwak, G.H.; Kim, M.S.; Kim, H.Y.; Hwang, K.Y. Structural Insights into a Bifunctional Peptide Methionine Sulfoxide Reductase MsrA/B Fusion Protein from Helicobacter pylori. Antioxidants 2021, 10, 389. [Google Scholar] [CrossRef]
- Eslami, S.M.; van der Donk, W.A. Proteases Involved in Leader Peptide Removal during RiPP Biosynthesis. ACS Bio. Med. Chem. Au 2023, 4, 20–36. [Google Scholar] [CrossRef] [PubMed]
- Chang, F.Y.; Brady, S.F. Cloning and characterization of an environmental DNA-derived gene cluster that encodes the biosynthesis of the antitumor substance BE-54017. J. Am. Chem. Soc. 2011, 133, 9996–9999. [Google Scholar] [CrossRef]
- Maleckis, M.; Wibowo, M.; Williams, S.E.; Gotfredsen, C.H.; Sigrist, R.; Souza, L.D.O.; Cowled, M.S.; Charusanti, P.; Gren, T.; Saha, S.; et al. Maramycin, a Cytotoxic Isoquinolinequinone Terpenoid Produced through Heterologous Expression of a Bifunctional Indole Prenyltransferase/Tryptophan Indole-Lyase in S. albidoflavus. ACS Chem. Biol. 2024, 19, 1303–1310. [Google Scholar] [CrossRef] [PubMed]
- Olasz, F.; Szabó, M.; Veress, A.; Bibó, M.; Kiss, J. The dynamic network of IS30 transposition pathways. PLoS ONE 2022, 17, e0271414. [Google Scholar] [CrossRef] [PubMed]
- Lysnyansky, I.; Calcutt, M.J.; Ben-Barak, I.; Ron, Y.; Levisohn, S.; Methé, B.A.; Yogev, D. Molecular characterization of newly identified IS3, IS4 and IS30 insertion sequence-like elements in Mycoplasma bovis and their possible roles in genome plasticity. FEMS Microbiol. Lett. 2009, 294, 172–182. [Google Scholar] [CrossRef]
- Sansevere, E.A.; Robinson, D.A. Staphylococci on ICE: Overlooked agents of horizontal gene transfer. Mob. Genet. Elem. 2017, 7, 1–10. [Google Scholar] [CrossRef] [PubMed]
- El Gharniti, F.; Dols-Lafargue, M.; Bon, E.; Claisse, O.; Miot-Sertier, C.; Lonvaud, A.; Le Marrec, C. IS30 elements are mediators of genetic diversity in Oenococcus oeni. Int. J. Food Microbiol. 2012, 158, 14–22. [Google Scholar] [CrossRef]
- Olucha, J.; Lamb, A.L. Mechanistic and structural studies of the N-hydroxylating flavoprotein monooxygenases. Bioorg. Chem. 2011, 39, 171–177. [Google Scholar] [CrossRef]
- Lewis, J.A.; Escalante-Semerena, J.C. The FAD-dependent tricarballylate dehydrogenase (TcuA) enzyme of Salmonella enterica converts tricarballylate into cis-aconitate. J. Bacteriol. 2006, 188, 5479–5486. [Google Scholar] [CrossRef] [PubMed]
- Liu, Z.; Huang, T.; Shi, Q.; Deng, Z.; Lin, S. Catechol siderophores framed on 2,3-dihydroxybenzoyl-L-serine from Streptomyces varsoviensis. Front. Microbiol. 2023, 14, 1182449. [Google Scholar] [CrossRef]
- Lu, P.; Dong, X.; Ji, X. Cronobacter sakazakii Pyridoxal Kinase PdxY Mediated by TreR and pESA3 Is Essential for Vitamin B6 (PLP) Maintenance and Virulence. Appl. Environ. Microbiol. 2023, 89, e0092423. [Google Scholar] [CrossRef] [PubMed]
- McGlinchey, R.P.; Nett, M.; Moore, B.S. Unraveling the biosynthesis of the sporolide cyclohexenone building block. J. Am. Chem. Soc. 2008, 130, 2406–2407. [Google Scholar] [CrossRef]
- Liang, M.H.; Zhu, J.; Jiang, J.G. Carotenoids biosynthesis and cleavage related genes from bacteria to plants. Crit. Rev. Food Sci. Nutr. 2018, 58, 2314–2333. [Google Scholar] [CrossRef]
- Han, E.J.; Seyedsayamdost, M.R. Genome mining for new enediyne antibiotics. Curr. Opin. Chem. Biol. 2024, 81, 102481. [Google Scholar] [CrossRef] [PubMed]
- Lohman, J.R.; Huang, S.X.; Horsman, G.P.; Dilfer, P.E.; Huang, T.; Chen, Y.; Wendt-Pienkowski, E.; Shen, B. Cloning and sequencing of the kedarcidin biosynthetic gene cluster from Streptoalloteichus sp. ATCC 53650 revealing new insights into biosynthesis of the enediyne family of antitumor antibiotics. Mol. Biosyst. 2013, 9, 478–491. [Google Scholar] [CrossRef]
- Thanapipatsiri, A.; Gomez-Escribano, J.P.; Song, L.; Bibb, M.J.; Al-Bassam, M.; Chandra, G.; Thamchaipenet, A.; Challis, G.L.; Bibb, M.J. Discovery of Unusual Biaryl Polyketides by Activation of a Silent Streptomyces venezuelae Biosynthetic Gene Cluster. ChemBioChem. 2016, 17, 2189–2198. [Google Scholar] [CrossRef]
- Song, R.; Shi, H.; Zhu, J.; Wang, H.; Shen, Y. A Single-Component Flavoenzyme Catalyzed Regioselective Halogenation of Pyrone in the Biosynthesis of Venemycins. ACS Chem. Biol. 2019, 14, 2533–2537. [Google Scholar] [CrossRef] [PubMed]
- Chen, J.; Zhang, S.; Chen, Y.; Tian, X.; Gu, Y.; Ju, J. Identification and Heterologous Expression of the Kendomycin B Biosynthetic Gene Cluster from Verrucosispora sp. SCSIO 07399. Mar. Drugs. 2021, 19, 673. [Google Scholar] [CrossRef] [PubMed]
- Lacey, H.J.; Chen, R.; Vuong, D.; Lacey, E.; Rutledge, P.J.; Chooi, Y.H.; Piggott, A.M.; Booth, T.J. Resorculins: Hybrid polyketide macrolides from Streptomyces sp. MST-91080. Org. Biomol. Chem. 2023, 21, 2531–2538. [Google Scholar] [CrossRef]
- Dinos, G.P. The macrolide antibiotic renaissance. Br. J. Pharmacol. 2017, 174, 2967–2983. [Google Scholar] [CrossRef]
- McCarty, R.M.; Bandarian, V. Deciphering deazapurine biosynthesis: Pathway for pyrrolopyrimidine nucleosides toyocamycin and sangivamycin. Chem. Biol. 2008, 15, 790–798. [Google Scholar] [CrossRef] [PubMed]
- Covington, B.C.; Spraggins, J.M.; Ynigez-Gutierrez, A.E.; Hylton, Z.B.; Bachmann, B.O. Response of Secondary Metabolism of Hypogean Actinobacterial Genera to Chemical and Biological Stimuli. Appl. Environ. Microbiol. 2018, 84, e01125-18. [Google Scholar] [CrossRef] [PubMed]
- Zhang, M.; Hou, X.F.; Qi, L.H.; Yin, Y.; Li, Q.; Pan, H.X.; Chen, X.Y.; Tang, G.L. Biosynthesis of trioxacarcin revealing a different starter unit and complex tailoring steps for type II polyketide synthase. Chem. Sci. 2015, 6, 3440–3447. [Google Scholar] [CrossRef] [PubMed]
- Torkkell, S.; Ylihonko, K.; Hakala, J.; Skurnik, M.; Mäntsälä, P. Characterization of Streptomyces nogalater genes encoding enzymes involved in glycosylation steps in nogalamycin biosynthesis. Mol. Gen. Genet. 1997, 256, 203–209. [Google Scholar] [CrossRef] [PubMed]
- Rackham, E.J.; Grüschow, S.; Ragab, A.E.; Dickens, S.; Goss, R.J. Pacidamycin biosynthesis: Identification and heterologous expression of the first uridyl peptide antibiotic gene cluster. ChemBioChem. 2010, 11, 1700–1709. [Google Scholar] [CrossRef]
- Zhang, W.; Ostash, B.; Walsh, C.T. Identification of the biosynthetic gene cluster for the pacidamycin group of peptidyl nucleoside antibiotics. Proc. Natl. Acad. Sci. USA 2010, 107, 16828–16833. [Google Scholar] [CrossRef]
- Zhang, W.; Ntai, I.; Bolla, M.L.; Malcolmson, S.J.; Kahne, D.; Kelleher, N.L.; Walsh, C.T. Nine enzymes are required for assembly of the pacidamycin group of peptidyl nucleoside antibiotics. J. Am. Chem. Soc. 2011, 133, 5240–5243. [Google Scholar] [CrossRef] [PubMed]
- Li, Q.; Wang, L.; Xie, Y.; Wang, S.; Chen, R.; Hong, B. SsaA, a member of a novel class of transcriptional regulators, controls sansanmycin production in Streptomyces sp. strain SS through a feedback mechanism. J. Bacteriol. 2013, 195, 2232–2243. [Google Scholar] [CrossRef] [PubMed]
- Kaysser, L.; Tang, X.; Wemakor, E.; Sedding, K.; Hennig, S.; Siebenberg, S.; Gust, B. Identification of a napsamycin biosynthesis gene cluster by genome mining. ChemBioChem 2011, 12, 477–487. [Google Scholar] [CrossRef] [PubMed]
- Saleh, O.; Gust, B.; Boll, B.; Fiedler, H.P.; Heide, L. Aromatic prenylation in phenazine biosynthesis: Dihydrophenazine-1-carboxylate dimethylallyltransferase from Streptomyces anulatus. J. Biol. Chem. 2009, 284, 14439–14447. [Google Scholar] [CrossRef]
- Bauman, K.D.; Li, J.; Murata, K.; Mantovani, S.M.; Dahesh, S.; Nizet, V.; Luhavaya, H.; Moore, B.S. Refactoring the Cryptic Streptophenazine Biosynthetic Gene Cluster Unites Phenazine, Polyketide, and Nonribosomal Peptide Biochemistry. Cell Chem. Biol. 2019, 26, 724–736. [Google Scholar] [CrossRef]
- Huang, W.; Wan, Y.; Su, H.; Zhang, Z.; Liu, Y.; Sadeeq, M.; Xian, M.; Feng, X.; Xiong, P.; Hou, F. Recent Advances in Phenazine Natural Products: Biosynthesis and Metabolic Engineering. J. Agric. Food Chem. 2024, 72, 21364–21379. [Google Scholar] [CrossRef] [PubMed]
- Smanski, M.J.; Casper, J.; Peterson, R.M.; Yu, Z.; Rajski, S.R.; Shen, B. Expression of the platencin biosynthetic gene cluster in heterologous hosts yielding new platencin congeners. J. Nat. Prod. 2012, 75, 2158–2167. [Google Scholar] [CrossRef] [PubMed]
- Maldonado, L.A.; Fenical, W.; Jensen, P.R.; Kauffman, C.A.; Mincer, T.J.; Ward, A.C.; Bull, A.T.; Goodfellow, M. Salinispora arenicola gen. nov., sp. nov. and Salinispora tropica sp. nov., obligate marine actinomycetes belonging to the family Micromonosporaceae. Int. J. Syst. Evol. Microbiol. 2005, 55, 1759–1766. [Google Scholar] [CrossRef] [PubMed]
- Fernández de Las Heras, L.; Alonso, S.; de la Vega de León, A.; Xavier, D.; Perera, J.; Navarro Llorens, J.M. Draft Genome Sequence of the Steroid Degrader Rhodococcus ruber Strain Chol-4. Genome Announc. 2013, 1, e00215-13. [Google Scholar] [CrossRef] [PubMed]
- Baldanta, S.; Navarro Llorens, J.M.; Guevara, G. Further Studies on the 3-Ketosteroid 9α-Hydroxylase of Rhodococcus ruber Chol-4, a Rieske Oxygenase of the Steroid Degradation Pathway. Microorganisms 2021, 9, 1171. [Google Scholar] [CrossRef] [PubMed]
- Guevara, G.; Olortegui Flores, Y.; Fernández de Las Heras, L.; Perera, J.; Navarro Llorens, J.M. Metabolic engineering of Rhodococcus ruber Chol-4: A cell factory for testosterone production. PLoS ONE 2019, 14, e0220492. [Google Scholar] [CrossRef]
- Mohn, W.W.; Wilbrink, M.H.; Casabon, I.; Stewart, G.R.; Liu, J.; van der Geize, R.; Eltis, L.D. Gene cluster encoding cholate catabolism in Rhodococcus spp. J. Bacteriol. 2012, 194, 6712–6719. [Google Scholar] [CrossRef]
- Guevara, G.; Castillo Lopez, M.; Alonso, S.; Perera, J.; Navarro-Llorens, J.M. New insights into the genome of Rhodococcus ruber strain Chol-4. BMC Genom. 2019, 20, 332. [Google Scholar] [CrossRef]
- Johnston, I.; Osborn, L.J.; Markley, R.L.; McManus, E.A.; Kadam, A.; Schultz, K.B.; Nagajothi, N.; Ahern, P.P.; Brown, J.M.; Claesen, J. Identification of essential genes for Escherichia coli aryl polyene biosynthesis and function in biofilm formation. npj Biofilms Microbiomes 2021, 7, 56. [Google Scholar] [CrossRef]
- Tsutsumi, H.; Katsuyama, Y.; Izumikawa, M.; Takagi, M.; Fujie, M.; Satoh, N.; Shin-Ya, K.; Ohnishi, Y. Unprecedented Cyclization Catalyzed by a Cytochrome P450 in Benzastatin Biosynthesis. J. Am. Chem. Soc. 2018, 140, 6631–6639. [Google Scholar] [CrossRef] [PubMed]
- Kong, L.; Xu, G.; Liu, X.; Wang, J.; Tang, Z.; Cai, Y.S.; Shen, K.; Tao, W.; Zheng, Y.; Deng, Z.; et al. Divergent Biosynthesis of C-Nucleoside Minimycin and Indigoidine in Bacteria. iScience 2019, 22, 430–440. [Google Scholar] [CrossRef] [PubMed]
- Yu, D.; Xu, F.; Valiente, J.; Wang, S.; Zhan, J. An indigoidine biosynthetic gene cluster from Streptomyces chromofuscus ATCC 49982 contains an unusual IndB homologue. J. Ind. Microbiol. Biotechnol. 2013, 40, 159–168. [Google Scholar] [CrossRef] [PubMed]
- Zhu, W.; Klinman, J.P. Biogenesis of the peptide-derived redox cofactor pyrroloquinoline quinone. Curr. Opin. Chem. Biol. 2020, 59, 93–103. [Google Scholar] [CrossRef]
- Cordell, G.A.; Daley, S.K. Pyrroloquinoline Quinone Chemistry, Biology, and Biosynthesis. Chem. Res. Toxicol. 2022, 35, 355–377. [Google Scholar] [CrossRef] [PubMed]
- Gao, H.; Wang, Y.; Yang, J.; Qiu, M.; Lei, Z.; Zhang, W.; Jiang, W.; Xin, F.; Jiang, M. Microbial synthesis of pyrroloquinoline quinone. World J. Microbiol. Biotechnol. 2023, 40, 31. [Google Scholar] [CrossRef]
- Okamoto, T.; Yamanaka, K.; Hamano, Y.; Nagano, S.; Hino, T. Crystal structure of the adenylation domain from an ε-poly-l-lysine synthetase provides molecular mechanism for substrate specificity. Biochem. Biophys. Res. Commun. 2022, 596, 43–48. [Google Scholar] [CrossRef] [PubMed]
- Yamanaka, K.; Maruyama, C.; Takagi, H.; Hamano, Y. Epsilon-poly-L-lysine dispersity is controlled by a highly unusual nonribosomal peptide synthetase. Nat. Chem. Biol. 2008, 4, 766–772. [Google Scholar] [CrossRef]
- Kito, M.; Takimoto, R.; Yoshida, T.; Nagasawa, T. Purification and characterization of an epsilon-poly-L-lysine-degrading enzyme from an epsilon-poly-L-lysine-producing strain of Streptomyces albulus. Arch. Microbiol. 2002, 178, 325–330. [Google Scholar] [CrossRef]
- Agrawal, R.; Goyal, V.D.; Kumar, A.; Gaur, N.K.; Jamdar, S.N.; Kumar, A.; Makde, R.D. Two-domain aminopeptidase of M1 family: Structural features for substrate binding and gating in absence of C-terminal domain. J. Struct. Biol. 2019, 208, 51–60. [Google Scholar] [CrossRef]
- Wang, L.; Zhang, C.; Zhang, J.; Rao, Z.; Xu, X.; Mao, Z.; Chen, X. Epsilon-poly-L-lysine: Recent Advances in Biomanufacturing and Applications. Front. Bioeng. Biotechnol. 2021, 9, 748976. [Google Scholar] [CrossRef]
- Fellner, M.; Lentz, C.S.; Jamieson, S.A.; Brewster, J.L.; Chen, L.; Bogyo, M.; Mace, P.D. Structural Basis for the Inhibitor and Substrate Specificity of the Unique Fph Serine Hydrolases of Staphylococcus aureus. ACS Infect Dis. 2020, 6, 2771–2782. [Google Scholar] [CrossRef] [PubMed]
- Dong, L.; Shen, Y.; Hou, X.F.; Li, W.J.; Tang, G.L. Discovery of Druggability-Improved Analogues by Investigation of the LL-D49194α1 Biosynthetic Pathway. Org. Lett. 2019, 21, 2322–2325. [Google Scholar] [CrossRef] [PubMed]
- de Lorenzo, V.; Neilands, J.B. Characterization of iucA and iucC genes of the aerobactin system of plasmid ColV-K30 in Escherichia coli. J. Bacteriol. 1986, 167, 350–355. [Google Scholar] [CrossRef]
- Mydy, L.S.; Bailey, D.C.; Patel, K.D.; Rice, M.R.; Gulick, A.M. The Siderophore Synthetase IucA of the Aerobactin Biosynthetic Pathway Uses an Ordered Mechanism. Biochemistry 2020, 59, 2143–2153. [Google Scholar] [CrossRef]
- Bailey, D.C.; Alexander, E.; Rice, M.R.; Drake, E.J.; Mydy, L.S.; Aldrich, C.C.; Gulick, A.M. Structural and functional delineation of aerobactin biosynthesis in hypervirulent Klebsiella pneumoniae. J. Biol. Chem. 2018, 293, 7841–7852. [Google Scholar] [CrossRef]
- Lee, Y.; Hyun, C.G. Anti-Inflammatory Effects of Psoralen Derivatives on RAW264.7 Cells via Regulation of the NF-κB and MAPK Signaling Pathways. Int. J. Mol. Sci. 2022, 23, 5813. [Google Scholar] [CrossRef]
- Kang, J.K.; Chung, Y.C.; Hyun, C.G. Anti-Inflammatory Effects of 6-Methylcoumarin in LPS-Stimulated RAW 264.7 Macrophages via Regulation of MAPK and NF-κB Signaling Pathways. Molecules 2021, 26, 5351. [Google Scholar] [CrossRef]
- Pourbagher-Shahri, A.M.; Farkhondeh, T.; Talebi, M.; Kopustinskiene, D.M.; Samarghandian, S.; Bernatoniene, J. An Overview of NO Signaling Pathways in Aging. Molecules 2021, 26, 4533. [Google Scholar] [CrossRef]

| Region | Type | From | To | Most Similar Known Cluster | Similarity |
|---|---|---|---|---|---|
| Region 1 | Terpene | 261,693 | 283,778 | Geosmin | 100% |
| Region 2 | Thiopeptide, LAP | 680,669 | 708,665 | Lactazole A | – |
| Region 3 | Terpene | 969,749 | 990,813 | 2-Methylisoborneol | 50% |
| Region 4 | Betalactone | 1,018,151 | 1,049,578 | Olefin, Cholesterol catabolism | 6% |
| Region 5 | Lanthipeptide-class-ii | 1,104,685 | 1,127,087 | – | |
| Region 6 | Terpene | 1,188,278 | 1,209,204 | Isorenieratene | 85% |
| Region 7 | Indole | 1,243,440 | 1,266,478 | BE-54017 | 85% |
| Region 8 | NRP-metallophore, NRPS, T1PKS | 1,394,523 | 1,504,164 | Sporolde A/B | 36% |
| Region 9 | NRPs, T1PKS, PKS-like | 1,668,991 | 1,752,869 | None | 1% |
| Region 10 | T3PKS, T1PKS, thioamide-NRP, NRPS-like | 1,761,348 | 1,875,228 | Venemycin | 13% |
| Region 11 | NRPS-like, T1PKS | 2,126,644 | 2,173,729 | None | 13% |
| Region 12 | NRPS, NRPS-like | 2,196,860 | 2,255,047 | Teicoplanin | 13% |
| Region 13 | Lanthipeptide-class-iv | 2,350,851 | 2,373,559 | – | |
| Region 14 | Arylpolyene | 2,670,065 | 2,711,225 | – | |
| Region 15 | NRPS | 2,926,396 | 2,999,505 | Lysolipin I | 4% |
| Region 16 | T1PKS, NRPS-like, Nucleoside | 3,135,054 | 3,288,715 | Queuosine | 35% |
| Region 17 | Hg1E-KS, T1PKS | 3,367,998 | 3,546,677 | Funisamine | 32% |
| Region 18 | NRPS-like | 3,876,808 | 3,920,068 | Benzastatins | 100% |
| Region 19 | Lanthipeptide-class-ii | 4,402,745 | 4,425,351 | – | |
| Region 20 | Indole | 4,704,733 | 4,725,827 | Maramycin | 6% |
| Region 21 | Lanthipeptide-class-v, RiPP-like | 4,766,909 | 4,808,848 | Pristinin A3 | 11% |
| Region 22 | RiPP-like | 4,885,434 | 4,896,252 | – | |
| Region 23 | Terpene | 5,100,398 | 5,123,964 | Isorenieratene | 28% |
| Region 24 | T2PKS, PKS-like, RiPP-like | 5,153,126 | 5,239,843 | Trioxacarcin | 39% |
| Region 25 | Lanthipeptide-class-iii | 5,253,745 | 5,276,303 | RiPP/Lanthipeptide | 75% |
| Region 26 | Terpene | 5,896,765 | 5,918,897 | Geosmin | 100% |
| Region 27 | C-nucleoside | 5,955,262 | 5,999,125 | Minimycin derivative | 80% |
| Region 28 | Redox cofactor | 6,385,027 | 6,407,063 | Pyrroloquinoline quinone | 26% |
| Region 29 | NAPAA | 8,425,356 | 8,459,093 | ε-Poly-L-lysine | 100% |
| Region 30 | None | 8,527,506 | 8,572,852 | 3% | |
| Region 31 | LAP, thiopeptide | 9,115,489 | 9,141,517 | – | |
| Region 32 | NI-siderophore | 9,879,565 | 9,910,373 | – | |
| Region 33 | NRPS-like, NRPS, T1PKS | 9,975,724 | 10,072,579 | Pacidamycin 1/2/3/4/5/6/7 DNRP | 77% |
| Region 34 | NRPS, phenazine, hg1E-KS | 10,131,339 | 10,205,680 | Phenazine derivatives | 11% |
| GenBank | Putative Functions | Proteins (Amino Acids) | Identity/ Similarity |
|---|---|---|---|
| XIJ15611 | LuxR-like transcription regulator | LjeR (917 aa)/AbeR (932 aa) | 79.06%/86.18% |
| XIJ15612 | RebP-like cytochrome P450 | LjeP (400 aa)/AbeP (392 aa) | 86.60%/92.06% |
| XIJ15613 | RebC-like FAD-monooxygenase | LjeC (525 aa)/AbeC (533 aa) | 89.87%/94.56% |
| XIJ15614 | RebO-like tryptophan oxidase | LjeO (501 aa)/AbeO (513 aa) | 90.27%/94.36% |
| XIJ15615 | Alpha/beta hydrolase | LjeY (262 aa)/AbeY (264 aa) | 86.74%/91.67% |
| XIJ15616 | Flavin reductase family protein | LjeF (160 aa)/AbeF (160 aa) | 89.38%/92.50% |
| XIJ15617 | Cation/proton antiporter | LjeT (411 aa)/AbeT (412 aa) | 84.93%/90.19% |
| XIJ15618 | Tryptophan halogenase | LjeH (515 aa)/AbeH (515 aa) | 95.15%/97.09% |
| XIJ15619 | O-methyltransferase | LjeM3 (336 aa)/AbeM3 (336 aa) | 89.32%/93.77% |
| XIJ15620 | FAD-dependent oxidoreductase | LjeX2 (413 aa)/AbeX2 (407 aa) | 92.03%/96.14% |
| XIJ15621 | Chromopyrrolic acid synthase | LjeD (1012 aa)/AbeD (1015 aa) | 93.10%/96.45% |
| XIJ15622 | N-methyltransferase | LjeM1 (231 aa)/AbeM1 (231 aa) | 90.91%/95.67% |
| XIJ15623 | FAD-dependent monooxygenase | LjeX1 (532 aa)/AbeX1 (533 aa) | 93.43%/96.81% |
| XIJ15624 | N-methyltransferase | LjeM2 (230 aa)/AbeM2 (230 aa) | 91.30%/93.91% |
| GenBank | Putative Functions | Venemycin (Identity/ Similarity) | Kendomycin (Identity/ Similarity) |
|---|---|---|---|
| XIJ19095 | Transcriptional regulator | Ken21 (33.73%/50.00%) | |
| XIJ16057 | Enoyl-CoA-hydratase DpgD | VemD 68.00%/79.64%) | Ken7 (73.33%/79.63%) |
| XIJ16058 | Enoyl-CoA hydratase/isomerase DpgC | VemC (54.24%/63.56%) | Ken4 (56.02%/64.52%) |
| XIJ16059 | 3,5-dihydroxyphenylacetyl-CoA synthase DpgA | VemA (65.61%/80.16%) | Ken2 (68.04%/77.06%) |
| XIJ16070 | Transcriptional regulator | VemR (38.90%/51.35%) | |
| XIJ16076 | Enoyl-CoA-hydratase DpgB | VemD (31.51%)/43.15%) | Ken3 (49.60%/62.30%) |
| XIJ16077 | NAD(P)/FAD-dependent oxidoreductase | Ken15 (46.40%/62.18%) | |
| XIJ16079 | Thiamine pyrophosphate-binding protein | VemE (31.30%/44.73%) | Ken5 (34.57%/46.36%) |
Disclaimer/Publisher’s Note: The statements, opinions and data contained in all publications are solely those of the individual author(s) and contributor(s) and not of MDPI and/or the editor(s). MDPI and/or the editor(s) disclaim responsibility for any injury to people or property resulting from any ideas, methods, instructions or products referred to in the content. |
© 2025 by the authors. Published by MDPI on behalf of the Hellenic Society for Microbiology. Licensee MDPI, Basel, Switzerland. This article is an open access article distributed under the terms and conditions of the Creative Commons Attribution (CC BY) license (https://creativecommons.org/licenses/by/4.0/).
Share and Cite
Hyun, K.-A.; Boo, K.-H.; Hyun, C.-G. Taxonomic Identification, Complete Genome Sequencing, and In Silico Genome Mining of the Actinobacterium Lentzea sp. JNUCC 0626 Isolated from Jeju Gotjawal. Acta Microbiol. Hell. 2025, 70, 8. https://doi.org/10.3390/amh70010008
Hyun K-A, Boo K-H, Hyun C-G. Taxonomic Identification, Complete Genome Sequencing, and In Silico Genome Mining of the Actinobacterium Lentzea sp. JNUCC 0626 Isolated from Jeju Gotjawal. Acta Microbiologica Hellenica. 2025; 70(1):8. https://doi.org/10.3390/amh70010008
Chicago/Turabian StyleHyun, Kyung-A, Kyung-Hwan Boo, and Chang-Gu Hyun. 2025. "Taxonomic Identification, Complete Genome Sequencing, and In Silico Genome Mining of the Actinobacterium Lentzea sp. JNUCC 0626 Isolated from Jeju Gotjawal" Acta Microbiologica Hellenica 70, no. 1: 8. https://doi.org/10.3390/amh70010008
APA StyleHyun, K.-A., Boo, K.-H., & Hyun, C.-G. (2025). Taxonomic Identification, Complete Genome Sequencing, and In Silico Genome Mining of the Actinobacterium Lentzea sp. JNUCC 0626 Isolated from Jeju Gotjawal. Acta Microbiologica Hellenica, 70(1), 8. https://doi.org/10.3390/amh70010008

